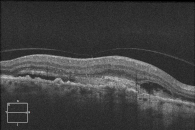

Altersbedingte Makuladegeneration (AMD)
Über 80 % unserer Umwelt erfassen wir über unsere Augen. Dabei spielt das zentrale Sehvermögen, das Scharfsehen, eine besondere Rolle, hängt doch davon die Lesefähigkeit ab. Dieses wird durch die Netzhautmitte, den nur wenige Quadratmillimeter großen „gelben Fleck“, die Makula, ermöglicht. Die altersbedingte Makuladegeneration ist zur häufigsten Ursache für die Sehverschlechterung bei Menschen über 50 Jahre geworden.
Mit zunehmendem Alter – bei 65-Jährigen sind es ca. 25 %, bei über 80-Jährigen ca. 40 % der Menschen – kommt es gerade in diesem Bereich zu Veränderungen oder Ablagerungen, zur altersbedingten Makuladegeneration. Sie kann in einer feuchten oder in einer trockenen Form auftreten. Erste Hinweise auf diese Erkrankung können ein zentraler grauer Fleck oder das Sehen von verzerrten Linien sowie eine Verschlechterung des Farbsehens sein.

 Links sehen Sie das Gesichtsfeld gesunder Augen. Rechts sehen Sie das durch AMD eingeschränkte Gesichtsfeld.
Links sehen Sie das Gesichtsfeld gesunder Augen. Rechts sehen Sie das durch AMD eingeschränkte Gesichtsfeld.Die trockene Makuladegeneration
Bei einer trockenen Makuladegeneration kommt es altersbedingt im Bereich der Makula zur Ablagerung von Stoffwechselprodukten der Netzhaut, den Drusen. Diese führen zu Durchblutungsstörungen der Netzhaut und in den Spätstadien zur Zerstörung von Sehzellen, was zu erheblichen Sehverschlechterungen führt.

 Links eine normale Netzhaut. Rechts eine Netzhaut mit Drusen.
Links eine normale Netzhaut. Rechts eine Netzhaut mit Drusen.Die feuchte Makuladegeneration
Bei einer feuchten Makuladegeneration wachsen als Folge von altersbedingten Stoffwechselstörungen neue krankhafte Blutgefäße unter die Makula. Diese werden undicht und führen zu Blutungen und teilweise zu Fettablagerungen und Wasseransammlungen. Die Netzhaut schwillt an. Das kann sehr schnell zum Sehverlust führen. Es gibt seit langem viele Therapie-Ansätze zur Behandlung dieser Erkrankung, um Sehverluste aufzuhalten.
feuchte Makuladegeneration
feuchte MakuladegenerationDie Unterscheidung zwischen einer trockenen und einer feuchten Makuladegeneration kann mit einer Fluoreszenzangiographie oder einer optischen Kohärenztomographie (OCT) erfolgen.
Bei der Fluoreszenzangiographie muss ein Kontrastmittel gespritzt werden, das in seltenen Fällen eine allergische Reaktion provozieren kann.
Die OCT-Untersuchung ist ein sogenanntes nichtinvasives Verfahren, ein Kontrastmittel ist nicht erforderlich. Außerdem erhalten wir mit dieser Untersuchung zusätzliche Erkenntnisse über den Zustand der einzelnen Netzhautschichten und des Sehnerven.
Behandlungsmöglichkeiten
Da es sich bei der Makuladegeneration um einen Alterungsprozess handelt, ist eine Heilung nicht möglich. Sie tritt, wie die Alterung überhaupt, in sehr vielfältigen Formen auf. Deshalb ist eine einheitliche Therapieempfehlung nicht möglich.
Behandlungsmöglichkeiten bei der feuchten Form der altersbedingten Makuladegeneration:
Durch die photodynamische Therapie werden die Gefäße netzhautschonend verödet. Diese beiden Behandlungsverfahren finden jedoch kaum noch Anwendung.
Die Behandlung der feuchten altersabhängigen Makuladegeneration hat sich in den vergangenen Jahren zunehmend in Richtung intravitreale Injektion, d.h. der Eingabe von Medikamenten in den Glaskörper des Auges, fortentwickelt. Derzeit werden die Antagonisten (Gegenspieler) eines „Gefäßneubildungsfaktores“ (VEGF), Lucentis und Eylea, zur Behandlung der AMD eingesetzt. Die Verabreichung erfolgt über eine kaum sichtbare Miniinzision, dauert nur wenige Minuten und wird unter streng sterilen Bedingungen unter lokaler Betäubung durchgeführt. In einigen ausgewählten Fällen kann die Behandlung mit einer photodynamischen Therapie (PDT) kombiniert werden. Diese wird in der Regel 16 bis 24 Stunden vor der Medikamenteneingabe vorgenommen.
Eine erfolgreiche AMD-Therapie ist durch eine allmähliche und kontinuierliche Verbesserung der Sehqualität gekennzeichnet. Das drückt sich z.B. darin aus, dass „weniger krumme Linien“ gesehen werden, der „grosse Fleck in der Mitte“ kleiner wird, und/oder Sie „mehr Prozente an der Lesetafel“ lesen können.
Eine Entscheidung über die Wahl der Therapie erfolgt nach einer Fluoreszenzangiographie und der optischen Kohärenztomographie.
Bei der feuchten altersbedingter Makuladegeneration ist für die Erhaltung des Sehvermögens die frühzeitige Erfassung und ein schneller Behandlungsbeginn sehr wichtig – je früher die Behandlung einsetzt, desto besser sind die Chancen, Ihr Sehvermögen zu erhalten und in einigen Fällen auch zu verbessern.
Behandlungsmöglichkeiten bei der trockenen Form der altersbedingten Makuladegeneration:
Die Therapie der altersbedingten Makuladegeneration führt zwar nicht bei allen Patienten zum Erfolg, es ist aber eine reale Chance das Fortschreiten der Erkrankung und damit die Zunahme des Sehverlustes zu stoppen. Ein Wiederherstellen verlorener Sehfähigkeit ist nicht möglich. Es ist deshalb besonders wichtig, die Erkrankung frühzeitig zu erkennen und zu behandeln.
